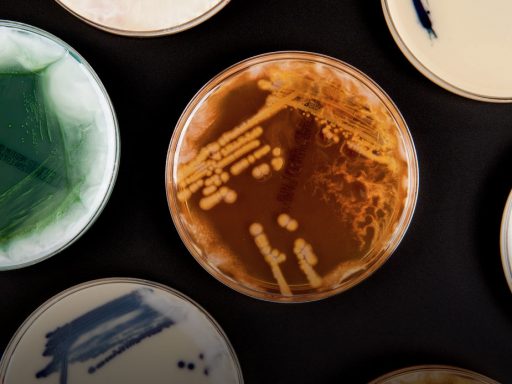

Discover the story behind Skylark, Britain’s first space rocket in a new exhibition.
From iconic galleries like Exploring Space to award-winning newer additions to the museum like Mathematics: The Winton Gallery our galleries make the museum an inspiring place to explore. We also open temporary exhibitions throughout the year covering a range of topics from science and technology to history and photography.

Discover the story behind Skylark, Britain’s first space rocket in a new exhibition.

Ninety nine years after the end of the First World War, curator Stewart Emmens looks at medical care both near the battlefield and at home.
From Neisseria gonorhoeae to living in space, did you know these 7 facts about bacteria?

Contemporary Science Volunteer Giulia Delprato talks about the latest development in burns treatment, SkinGun.

On this day in 1889 the Modernist painter Edward Wadsworth was born. Assistant Curator Rupert Cole explores an interaction Wadsworth had with Science Museum objects in the 1930s.

We spoke to our wonderful Power UP ambassadors to find out what their favourite retro gaming memories were and why those games were so special.

Inspired by the growing number of female gamers attending Power UP this year, we take a look at the rise in female developers.

Before they go on display, our objects undergo thorough checks and sometimes require repairs. HLF Conservation Intern, Matt Walker, talks us through the process of repairing one such object.

Today Hindus, Jains, Sikhs and Buddhists around the world celebrate the auspicious festival of Diwali.

Simonetta Di Pippo, Director of UNOOSA, explains the history and importance of the Outer Space Treaty

On 3 October 2017 the Science Museum opened new season Illuminating India to VIP guests.

Explore the story behind Cassini – a spacecraft that has been exploring the Saturnian system since 2004.